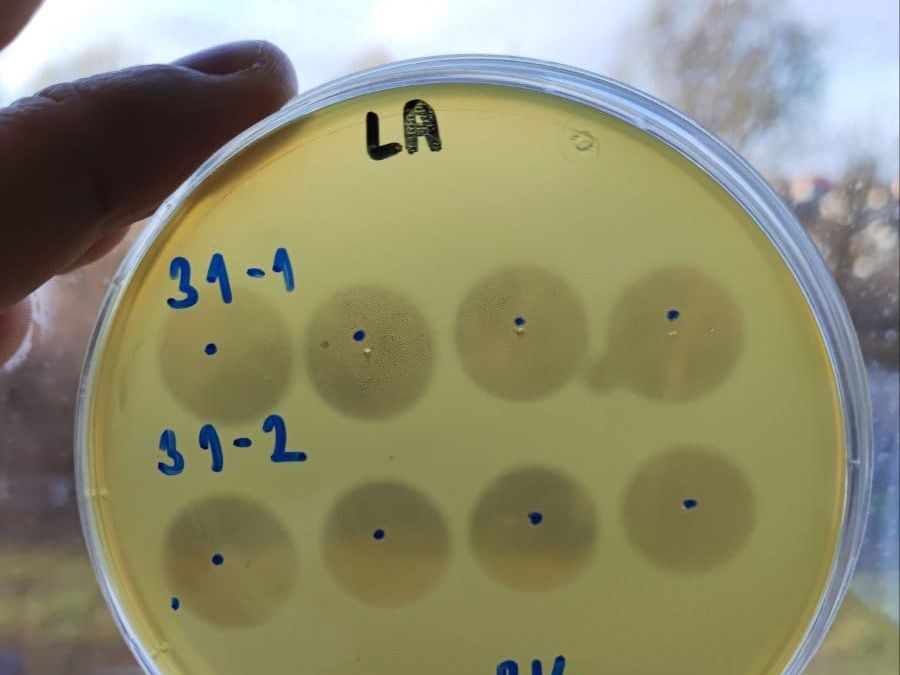
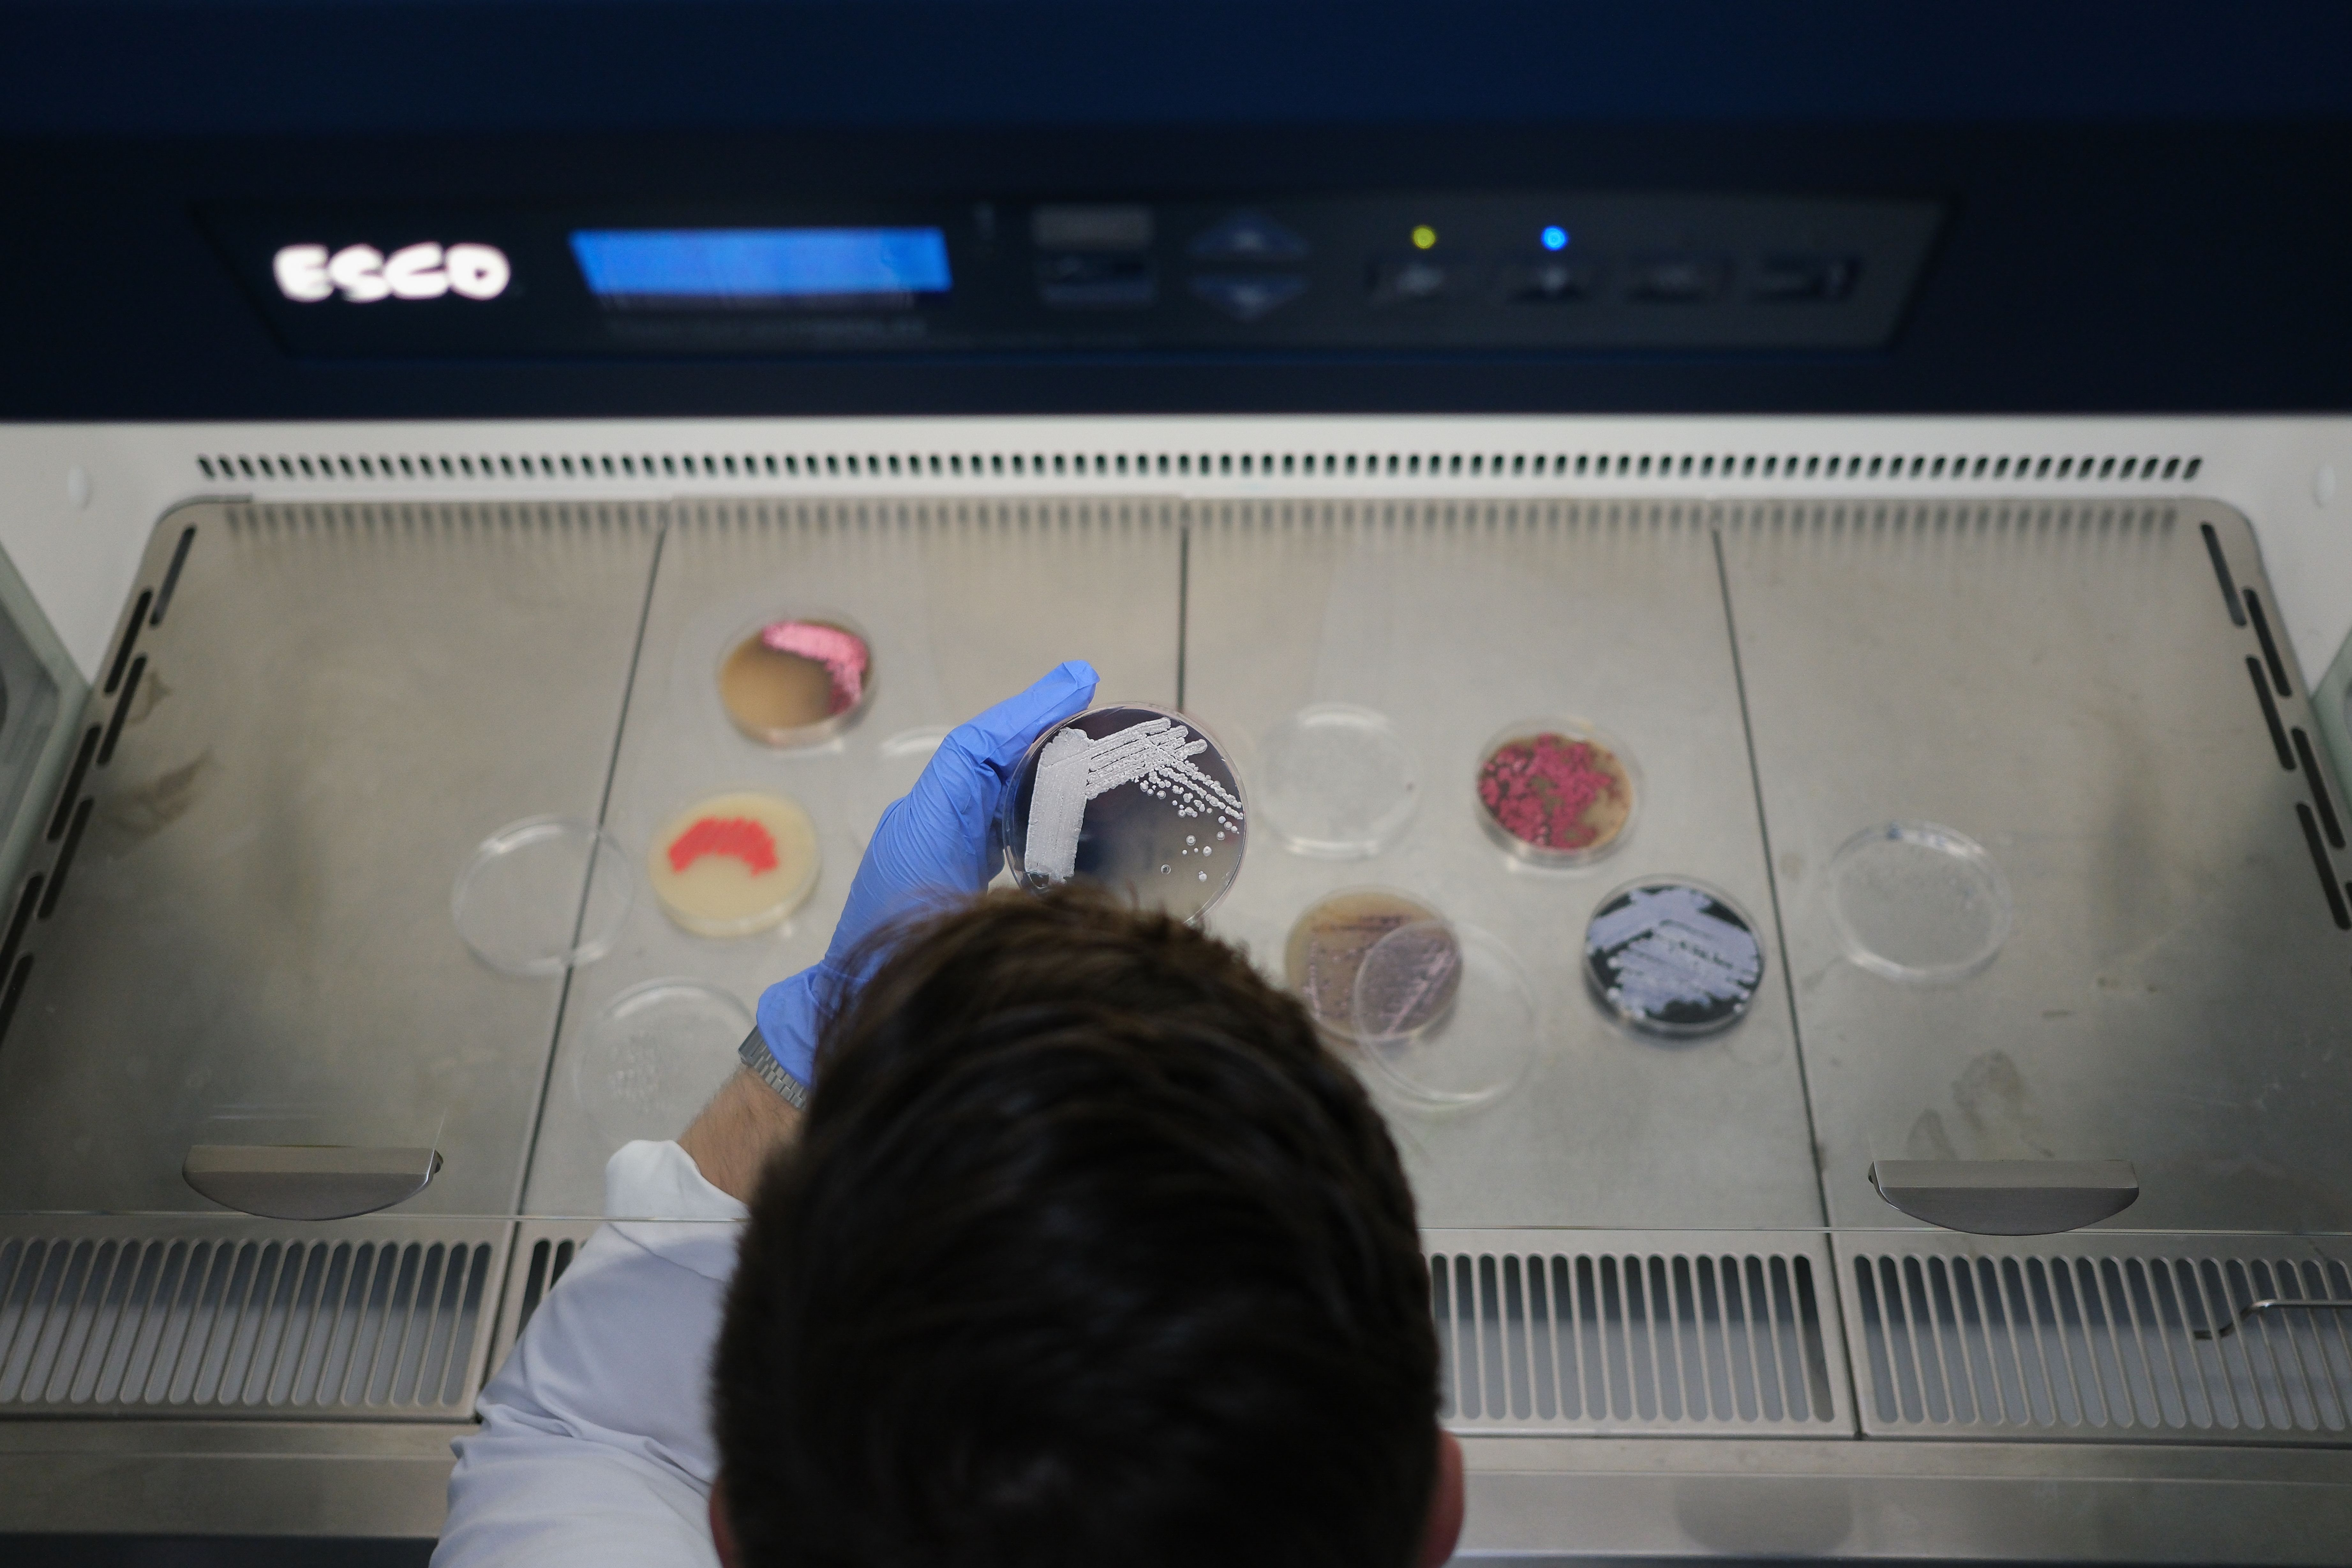

Kalendar događaja
Dugi niz godina, poslovna politika IMGGI podrazumeva odgovoran i posvećen pristup prema građanstvu, usmeren ka unapređenju obrazovanja mladih i popularizaciji nauke, kroz različite programe i projekte.
-
Kontakt osoba: dr Danijela Stanisavljević Ninković, danijela.stanisavljevic@imgge.bg.ac.rs

Međunarodni dan obrazovanja
Generalna skupština Ujedinjenih nacija proglasila je 24. januar za Međunarodni dan obrazovanja, u čast uloge obrazovanja u postizanju globalnog mira i održivog razvoja.

Svetski dan borbe protiv raka
U cilju povećanja pažnje i edukacije javnosti o značaju ranog otkrivanja raka, u svetu 4. februara obeležava Svetski dan borbe protiv raka.

Međunarodni dan žena i devojaka u nauci
Svake godine 11. februara svet slavi Međunarodni dan žena i devojčaka u nauci. Ovaj dan je ustanovljen na Generalnoj skupštini UN 22. decembra 2015. godine, sa ciljem da podstakne žene i devojke da se odluče za karijere u nauci i naučno povezanim oblastima.

Međunarodni dan retkih bolesti
Od svog osnivanja 2007. godine, Međunarodni dan retkih bolesti se svake godine obeležava poslednjeg dana februara. Postoji više od 7000 poznatih vrsta retkih bolesti, dok oko 300 miliona ljudi živi sa retkim bolestima.

Nedelja svesti o mozgu
Nedelja svesti o mozgu je naučno-popularna manifestacija koja se svake godine organizuje u martu i posvećena je podizanju svesti javnosti o napretku i mogućoj primeni saznanja dobijenih istraživanjem nervnog sistema. Tokom Nedelje svesti o mozgu organizuju se predavanja i radionice za različite uzraste, sve u cilju obrazovanja i informisanja šire javnosti o funkcionisanju i zdravlju mozga.

Dan matičnih ćelija
Najveća međunarodna manifestacija posvećena popularizaciji matičnih ćelija, koja se održava istovremeno na brojnim univerzitetskim centrima širom Evrope. Inicijator i koordinator događaja je UniStem centar za istraživanje matičnih ćelija sa Univerziteta u Milanu. Imajući u vidu značaj matičnih ćelija, pre svega u oblasti regenerativne medicine, biologija matičnih ćelija trenutno je jedno od najaktuelnijih i najdinamičnijih polja istraživanja na svetu, koje sve više dobija na značaju i u našoj zemlji. Cilj događaja je da približi svet matičnih ćelija domaćoj javnosti i pruži priliku za upoznavanje sa revolucionarnim otkrićima koja pomeraju granice savremene medicine. Takođe, srednjoškolcima se pruža prilika da steknu nova znanja o naučno-istraživačkom radu kroz direktnu interakciju sa istraživačima i obilazak laboratorija.

Dan DNK
Svake godine 25. aprila slavi se godišnjica otkrića dvostruke spirale deoksiribonukleinske kiseline (DNK) (1953). Ovaj dan IMGGI posvećuje doktorskim studentima i organizuje mini simpozijum i predavanja za studente kao podsećanje na sve mogućnosti, otkrivene i još uvek neotkrivene, koje nam genetika nudi.

Međunarodni dan fascinacije biljkama
Dan fascinacije biljkama se globalno obeležava 18. maja, podstičući ljude da se dive čudima biljaka i njihovom ogromnom značaju u našim životima, za poljoprivredu, hortikulturu, šumarstvo i farmaciju.

Međunarodni dan biološke raznovrsnosti
Međunarodni dan biološke raznovrsnosti se obeležava 22. maja, a podseća nas na važnost očuvanja prirodnih ekosistema i zaštite različitih vrsta na našoj planeti. Ovaj dan ima za cilj da podiže svest o tome kako biološka raznovrsnost doprinosi održivom razvoju i dobrobiti ljudi, životinja i biljaka.

Svetski dan zaštite životne sredine
Svetski dan zaštite životne sredine obeležava se svake godine 5. juna širom sveta kroz različite aktivnosti i kampanje, sa ciljem da se skrene pažnja javnosti na brojne ekološke probleme i potrebu za očuvanjem životne sredine.

Svetski dan mikrobioma
Ovaj dan je posvećen povećanju svesti i obrazovanju o tome koliko su mikrobi važni za zdravlje ljudi, životinja, biljaka, okeana i cele planete.

Dan nauke u Srbiji
Nacionalni dan nauke, koji se obeležava 10. jula, ujedno je i rođendan našeg velikog naučnika Nikole Tesle. Ovaj dan je posvećen sećanju na Tesline izume i njegov ogroman doprinos nauci i tehnologiji. Dan nauke podstiče razvoj istraživanja i inovacija u Srbiji, inspirišući nove generacije da slede Teslina dostignuća i doprinesu naučnom napretku.

Međunarodni dan mikroorganizama
Međunarodni dan mikroorganizama ima za cilj podizanje svesti o značaju mikroorganizama u našem svakodnevnom životu.

Evopska noć istraživača
Noć istraživača Evrope slavi i promoviše nauku širom Evrope svake godine, poslednjeg petka u septembru. Ako ste ljubitelj nauke, ovo je sjajno mesto za otkrivanje fascinantnog sveta nauke na zabavan i interaktivan način – sa porodicom, prijateljima, kolegama ili sami.

Svetski dan nauke za mir i razvoj
Svetski dan nauke se svake godine obeležava 10. novembra, a ovaj dan ističe značajnu ulogu nauke u društvu i potrebu da se šira javnost uključi u diskusiju o novim naučnim pitanjima. Dan takođe naglašava značaj i relevantnost nauke u svakodnevnom životu.
Svetska nedelja svesti o antibioticima
Ova nedelja se obeležava od 18. do 24. novembra svake godine sa ciljem poboljšanja svesti i razumevanja antimikrobne otpornosti.


